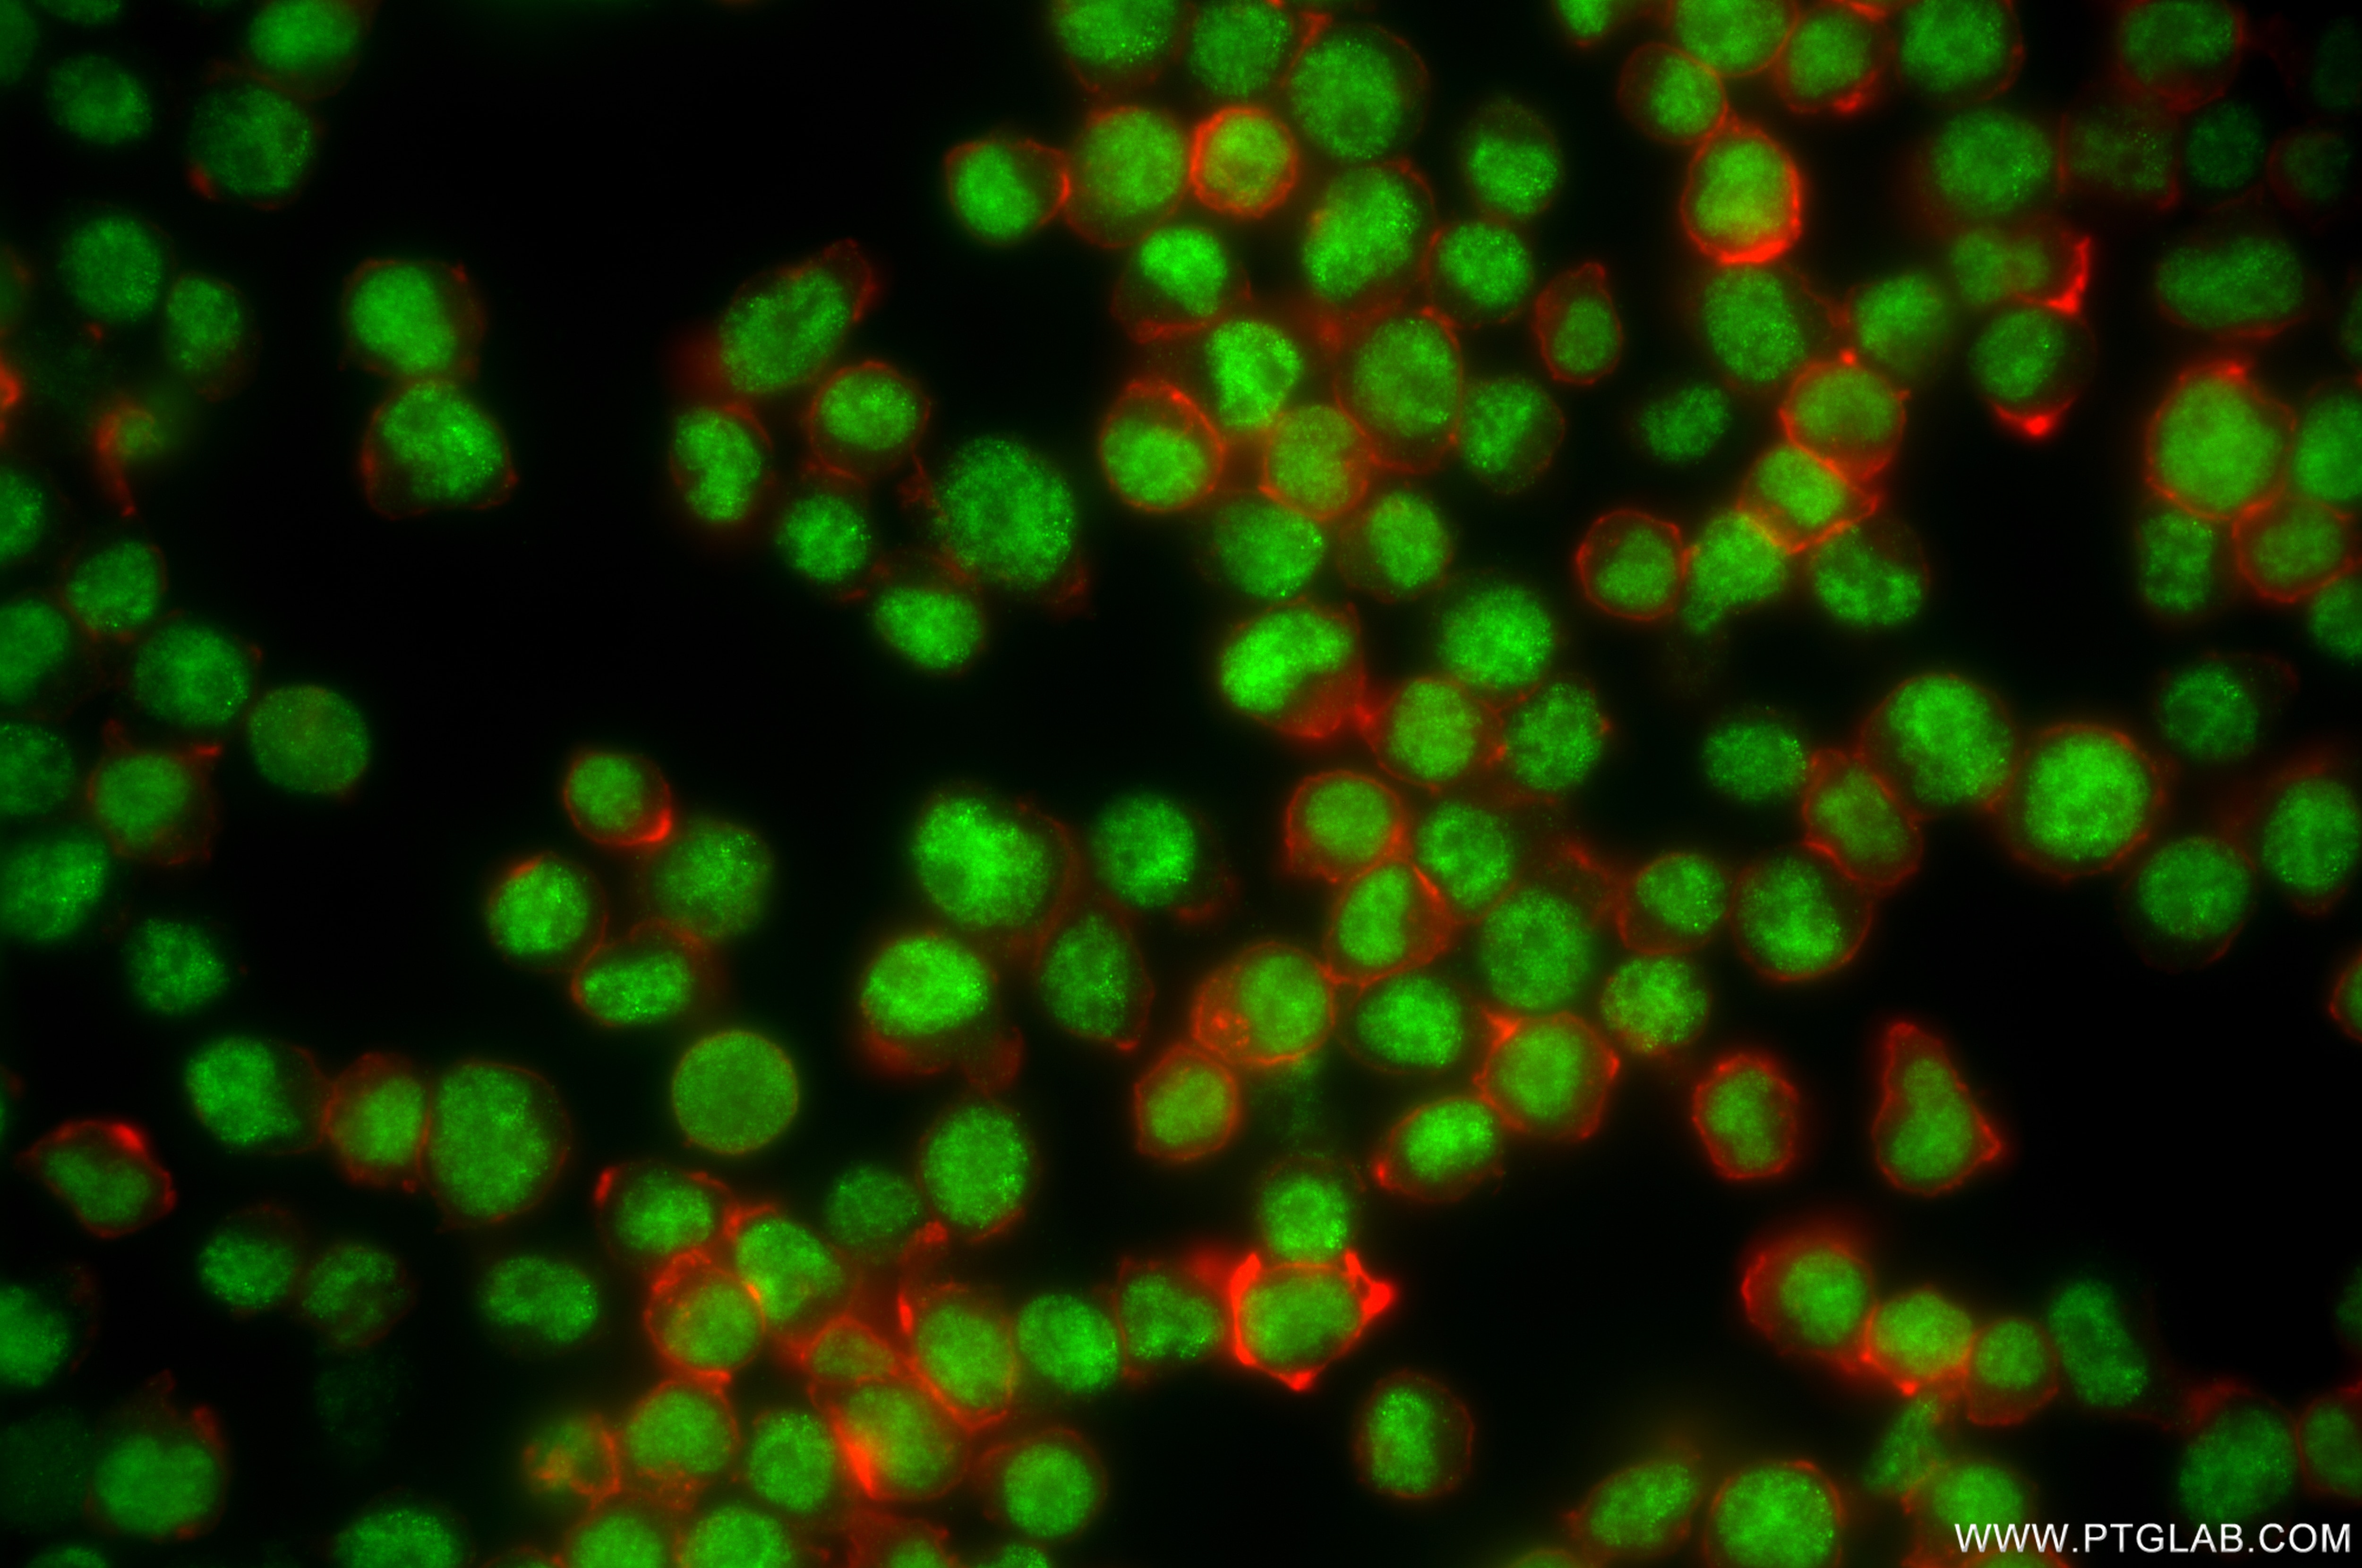
Immunofluorescence (IF) / fluorescent staining of Jurkat cells using PRPF31 Recombinant antibody (86315-2-RR)

Tested Applications
| Positive WB detected in | Jurkat cells, HeLa cells, A549 cells, Caco-2 cells, OVCAR-3 cells |
| Positive IF/ICC detected in | Jurkat cells, HeLa cells |
Recommended dilution
| Application | Dilution |
|---|---|
| Western Blot (WB) | WB : 1:5000-1:50000 |
| Immunofluorescence (IF)/ICC | IF/ICC : 1:250-1:1000 |
| It is recommended that this reagent should be titrated in each testing system to obtain optimal results. | |
| Sample-dependent, Check data in validation data gallery. | |
Product Information
86315-2-RR targets PRPF31 in WB, IF/ICC, ELISA applications and shows reactivity with human samples.
| Tested Reactivity | human |
| Host / Isotype | Rabbit / IgG |
| Class | Recombinant |
| Type | Antibody |
| Immunogen |
CatNo: Ag26716 Product name: Recombinant human PRPF31 protein Source: e coli.-derived, PGEX-4T Tag: GST Domain: 101-212 aa of NM_015629 Sequence: MVEIENELNIIHKFIRDKYSKRFPELESLVPNALDYIRTVKELGNSLDKCKNNENLQQILTNATIMVVSVTASTTQGQQLSEEELERLEEACDMALELNASKHRIYEYVESRM Predict reactive species |
| Full Name | PRP31 pre-mRNA processing factor 31 homolog (S. cerevisiae) |
| Calculated Molecular Weight | 55 kDa |
| Observed Molecular Weight | 55-60 kDa |
| GenBank Accession Number | NM_015629 |
| Gene Symbol | PRPF31 |
| Gene ID (NCBI) | 26121 |
| Conjugate | Unconjugated |
| Form | Liquid |
| Purification Method | Protein A purification |
| UNIPROT ID | Q8WWY3 |
| Storage Buffer | PBS with 0.02% sodium azide and 50% glycerol, pH 7.3. |
| Storage Conditions | Store at -20°C. Stable for one year after shipment. Aliquoting is unnecessary for -20oC storage. 20ul sizes contain 0.1% BSA. |
Background Information
PRPF31 is a component of the spliceosome complex. It is recruited to introns following the attachment of U4 and U6 RNAs and the 15.5K protein. The addition of PRPF31 is crucial for the transition of the spliceosomal complex to the activated state.
Protocols
| Product Specific Protocols | |
|---|---|
| IF protocol for PRPF31 antibody 86315-2-RR | Download protocol |
| WB protocol for PRPF31 antibody 86315-2-RR | Download protocol |
| Standard Protocols | |
|---|---|
| Click here to view our Standard Protocols |